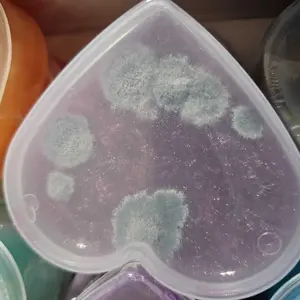

- TikTok Shop
- Toys & Hobbies
- Classic & Novelty Toys
- Slime & Squishy Toys
- 30Pcs Cosmic Realm Valentine Slime with Scratch-Off Cards and Galaxy Balls for Kids Classroom Exchange Gift Valentines Slime with Kids Valentines Cards 2025 Valentine Exchange Cards Gifts for Kids &Heart Shape Galaxy Slime with Cards, 30 Packs










4.6
1203 global reviews
5
1010
4
70
3
34
2
27
1
62
Photos from reviews
Sort by
Recommended
Filter by
All
Displaying 1203 of 1203 reviews
Reset filters
S**i
·
Verified purchase
US
Seriously, the cutest Valentines I’ve ever seen! Incredible quality, comes with everything you need and I love that They also are scratch art on the back! I’m happy I got them early before they sell out


Item:
Default2024-12-20

M**e V**z
·
Verified purchase
US
Material: Was is stiff even trying to play with it it does not stretch
Product quality: Hard not not pliable

Item:
30pcs slime(Fantasy)2026-02-02
F**🌊
·
Verified purchase
US
Box came in a bad condition, I’m surprised none busted open. This is shipped in a plastic bag just a heads up.



Item:
30Pcs Galaxy Balls Slime2026-01-14

e**4
·
Verified purchase
US
These are the biggest PITA to put together! The slime won't stay on the space on the card and the plastic bag/envelope is BARELY big enough to close without taping TO the Valentine card. 0/10 would not buy again. My 8 yr old couldn't put them together and I had to spend over an hour fighting with it



Item:
30Pcs Galaxy Balls Slime2025-02-13

p**b
·
Verified purchase
US
I love these I bought them for the boys and girls in my son’s class.



Item:
30Pcs Galaxy Balls Slime2025-01-30

F**y
·
Verified purchase
US
Box came in completely opened with missing items.



Item:
30Pcs Galaxy Balls Slime2026-01-22

T**e T**s T**e T**t
·
Verified purchase
US
Both my kids loved this idea for their Valentine’s Day gifts to their classmates. It was time consuming to put together but with teamwork it took a good 20 mins each box to write the names and pack in the bags. Great alternative than giving out candy 🍭


Item:
30Pcs Galaxy Balls Slime2026-02-13

A**n
·
Verified purchase
US
I love these as valentines! The slime is not sticky like some slimes are, it’s a great consistency, then the cards being scratch design cards gives the kids a second thing to do! They’re great! The only thing wrong was one card was dipped wrong, but had a few extra, so it was ok for my purposes :)


Item:
30Pcs Galaxy Balls Slime2026-02-12
b**4
·
Verified purchase
US
These are great. Doesn't stick in hair but be careful because it will stick to clothes


Item:
30Pcs Galaxy Balls Slime2026-01-29

E**s
·
Verified purchase
US
The perfect valentines classroom gift for kids! So much fun, super stretchy, doesn’t stick to your clothes, hair or carpets which is what sold me on this one. My kid loved and I’m sure her classmates will love too!


Item:
30Pcs Galaxy Balls Slime2026-01-12

B**y ** **
·
Verified purchase
US
My box was opened and tore and one ball was smashed/melted opened. Very disappointing


Item:
30Pcs Galaxy Balls Slime2026-01-10

D**e
·
Verified purchase
US
Package came already ripped open. Looks like everything is in there, but the scratch cards aren't exactly mint.


Item:
30Pcs Galaxy Balls Slime2026-01-10

K**y S**y
·
Verified purchase
US
Opened one heart when we first got it and put it back in the box. We were going to assemble them today for class party on Friday, and it is molded!

Item:
30Pcs Heart-Shaped Slime2025-02-11

A**s ** A**a
·
Verified purchase
US
These are absolutely perfect for my son’s class valentines! They aren’t messy and the colors are so cute. The scratch cards are an awesome touch as well! Exceeded my expectations!


Item:
30Pcs Galaxy Balls Slime2025-01-29
S**y
·
Verified purchase
US
This will be a great for my son’s Valentine’s Gifts for his class. The TikToker said this was unique, and it sure is! I was nervous, because I saw a review where he/she said it came and the slime wasn’t in “balls”. Mine came as shown! Very pleased.


Item:
30Pcs Galaxy Balls Slime2025-01-10

J**e
·
Verified purchase
US
Not slime and 1/2 of the containers grew mold.


Item:
30Pcs Heart-Shaped Slime2025-02-09

🩵**️
·
Verified purchase
US
Great product for kids. Was easy to assemble. Makes great gift for the class .
Item:
30pcs Heart Shape slime2026-02-09

B**h W**s
·
Verified purchase
US
The packaging was good and colors are
Beautiful. But the slime is hard and breaks apart when stretched the slightest little bit.
Item:
30pcs Heart Shape slime2026-02-09

K**
·
Verified purchase
US
These are perfect. Great alternative to candy and inspires kiddos to draw their own artwork and play with the slime. Love them!
Item:
30Pcs Galaxy Balls Slime2026-02-05

A**V
·
Verified purchase
US
I we disappointed I thought I was was getting the space cards for boy’s. Instead I received girls one.

Item:
30pcs slime(Fantasy)2026-02-05
About this product
-33%$21.99$32.99
Free shipping
30Pcs Cosmic Realm Valentine Slime with Scratch-Off Cards and Galaxy Balls for Kids Classroom Exchange Gift Valentines Slime with Kids Valentines Cards 2025 Valentine Exchange Cards Gifts for Kids &Heart Shape Galaxy Slime with Cards, 30 Packs
4.7(1.2K)
22.0K sold
Style:30pcs Galaxy Slime Heart
 30Pcs Galaxy Balls Slime
30Pcs Galaxy Balls Slime 30pcs Heart Shape slime
30pcs Heart Shape slime 30pcs slime(Fantasy)
30pcs slime(Fantasy) 30pcs Galaxy Slime Heart
30pcs Galaxy Slime HeartQuantity:
Coupon center
Log in to check your coupons
View and claim any available offers once you're logged in.
Shipping & returns
Shipping & delivery
Many items qualify for free shipping or become eligible once the order threshold is met.
Returns made easy
Most items are eligible for free returns within 30 days of delivery for a refund. Some items, including ingestibles, hygiene products, and pre-owned goods, are non-returnable. Final sale items cannot be returned or replaced.
About this shop

Joyfy-US
Gold Star Seller
4.5
690.2K Sold
64.9K+ Followers
99%24h response rate
61%Ships within 2 days
87%Positive feedback
Visit
Shop review
Videos for this product
Creator earns commission
Chanci with an 👁️
81.2K
Creator earns commission
Max Blandford
60.3K
Creator earns commission
Allie’s favorite finds 🌟
46.5K
Creator earns commission
🎀Alisha🎀
35.1K
Creator earns commission
Ben Slater
30.1K
Creator earns commission
Nurse Practitioner Natalie
20.3K
Creator earns commission
shopcozyhollow
14.1K
Creator earns commission
J E N N A 🛍️ Z O L O
14.0K
Creator earns commission
Jenthepiercer
13.8K
Creator earns commission
heysaranicol
11.8K
Creator earns commission
Heathergrace
11.7K
Creator earns commission
shopwithshelby
11.6K
Creator earns commission
Emma | ID 🗝️
10.3K
Creator earns commission
Angie 💕 TTS
10.1K
Creator earns commission
shopwithshelby
9.4K
Creator earns commission
CarrieH1972
9.2K
Creator earns commission
🎀Alisha🎀
9.2K
Creator earns commission
rose soma
8.3K
Creator earns commission
Hannah | mom of 3
6.7K
Creator earns commission
Ben Slater
6.6K
Explore more from Joyfy-US
You may also like
People also searched for



















